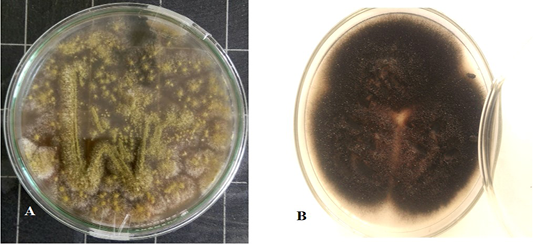

Advances in Animal and Veterinary Sciences
Granulomatous lesions on the lateral (A) and medial (B) surfaces of camel lung which showing fetid grey purulent material.
Aspergillus Flavus culture with velvety surface, olive green color(A) and Alternaria alternata culture cottony grey to olive brown colonies on the surface with short aerial hyphae (B).
Light microscope examination shows heavy walled, coarsely roughened conidiophores and globose to subgloboseconidiaindicating to A. flavus (A). Other conidia are brown in color with an elongated apical cell typically in chains and Conidiophores are septate indicating to Alternaria species (B).
SEM of A.flavus A and B showing 10 µm,1000x and 2000x a highly magnified photo for the shape of conidiophores which ends with small head bearing uniseriatephialides terminates with a tight chains of conidia which are globose. C and D show SEM of 20 µm 850x magnified and 10um 2.300 x of Alternaria alternata with simple unbranched and branched conidial chains of moderate length
Dendrogram of A. flavus isolate showing its identity with public library. The amplified gene 1141 (bp) was used to insert the organism in its position in the phylogenetic tree.
Dendrogram of Alternaria alternata isolate showing its identity with public library. The amplified gene 551 (bp) was used to insert the organism in its position in the phylogenetic tree.